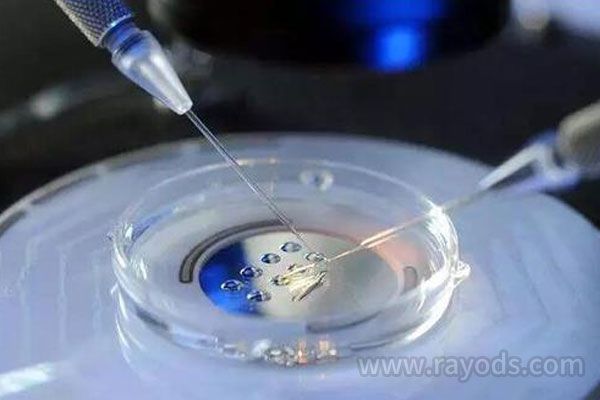
美国试管婴儿成功率高吗？会百分百成功吗？

-
父母会百分百遗传给孩子这些特征
孩子会与父母有很多相同之处,如身型高矮、身材瘦胖、皮肤的颜色、眼睛大小、鼻子高低……许多都和父母的遗传有关,什么叫会100%遗传呢?1、寿命这是有遗传基本的。我们可..
2023-02-12 14:00 -

没有百分百生龙凤胎的秘诀,提高生龙凤胎几率和5个方法你一定要知道?
没有百分百生龙凤胎的秘诀,提高生龙凤胎几率和5个方法你一定要知道?正常怀孕情况下,如果你想怀上龙凤胎,那么概率是千分之一到千分之五,双胞胎中怀上龙凤胎的概率只有2..
2023-03-09 16:00 -

三代试管并不是百分百的儿子!试管生男孩生女孩的概率分析?
三代试管并不是百分百的儿子!试管生男孩生女孩的概率分析?试管技术,三代试管都不是100%的生儿子。三代试管只筛选染色体和遗传病基因。严格来说,三代试管生男孩和女孩的..
2023-05-03 11:23 -

和合术百分百成功挽回感情吗?道教和合术成功的
有人听说道家和合术可以达到100%和好的效果,这里需要告诉你,并没有一项法事或者法术可以保证达到100%的效果。因为需要看的因素很多,需要注意的是在选择做法的时候需要有..
2023-07-22 08:49 -
香港做第三代试管婴儿能百分百包生男孩有前提
虽然香港第三代试管婴儿技术上可以筛查胎儿的性别,但是医院并不会随意按照夫妻双方的意愿来选择胎儿的性别,因为中国明令禁止非医学需要鉴定胎儿性别和选择性终止妊娠。因..
2023-07-25 13:18 -

和合术百分百成功吗?做和合术有什么反应
和合术是中国道教流传下来的让感情破裂后重新挽回感情的秘术,出轨外遇等感情出现问题后很多人使用和合术挽回,不过和合术百分百成功吗?做和合术有什么反应?和合术百分百成..
2023-08-04 14:27 -

不知道怎样能怀上孕 百分百怀孕的方法请掌握
孩子是一个家庭的枢纽,是父母爱情的结晶,是希望,是血脉的延续,所以在年轻人结婚以后,都会想要一个属于自己的孩子,但是受到现在生活习惯和生活方式的影响,现在的年轻..
2023-08-11 07:40 -

国内私立医院做第三代试管婴儿真的可以百分百要男女吗?附详细条件?
三代试管婴儿真的可以百分百要男女吗?附详细条件?不孕症已经成为许多夫妇的一个问题。当然,不孕的原因有很多。有些夫妻是因为自身血型的原因无法受孕,有些则是因为长期..
2023-08-28 12:22 -

了解一次就中的几率有多少 提升命中率百分百
一次就中的几率有多少?女性能够顺利的受孕这其中也包含着技术含量,有的夫妻结婚多年却一直都备孕无果,如果不是夫妻双方身体有毛病,那么,剩下的就是同房时机不对,同房..
2023-08-29 07:26 -

国内私立医院做第三代试管婴儿真的可以百分百要男女吗?附详细流程?
三代试管婴儿真的可以百分百要男女吗?附详细流程?可以选择胎儿的性别。但是这种做法是违法的,所以目前全世界的第三代试管婴儿移植技术都不允许对胎儿进行性别选择。在试..
2023-08-29 11:39 -

和合术并非百分百成功 这些情况就不行
都说和合术对于促进或挽回感情是非常有效果的,平时生活当中,如果感情出现了一些问题,或者是想要提升一下自己的桃花运,大家或多或少都想要去试试和合术。尽管和合术的成..
2023-08-30 16:54 -

备孕的夫妻都想知道 百分百生龙凤胎的秘诀
现在人们都是想要生一个女儿和生一个儿子,这样才能凑一个好字,但是人们很多的人一般都是一胎生一个,如果是想要生两个的话,那么就要受两次罪,当然一次性成功怀上龙凤胎..
2023-09-11 07:42 -

三代试管真的可以百分百要男女吗?选男孩要花多少钱?
三代试管真的可以百分百要男女吗?选男孩要花多少钱?三代试管婴儿技术因其高级的胚胎筛选能力在近年来备受关注,尤其是在性别选择方面。然而,许多人关心的问题是,这项技术..
2024-01-19 09:29 -

5个方法助你生出龙凤胎-百分百生龙凤胎的秘诀 ,试过的人都说准!
相信很多女性在看到别人家的龙凤胎宝宝的时候都会羡慕不已。作为女性生孩子的时候谁都想一次抱俩,儿女双全,那就两全其美了,还可以免受一次分娩的痛苦。今天小编就为大家..
2024-03-08 09:35 -
美国试管婴儿成功率高吗?会百分百成功吗?
美国试管婴儿成功率高吗?会百分百成功吗?很多有赴美试管意向的人都会考虑这个问题,因为这会直接关系到自己投入时间和金钱,还可能会影响自己的工作,所以只有详细了解之后..
2024-04-07 09:24 -

百分百生男孩的方法,分享我的备孕男宝成功绝招
说起生男生女,不少人都在打听百分百生男孩的方法。想要通过一些所谓的生男孩秘方,来帮助生男孩。但是真的有百分百生男孩的方法吗?很诚恳的告诉大家,所谓的百分百生男孩..
2024-06-12 09:24 -

百分百成功的和合术,可信吗?
我在贴吧上看到了和睦方法介绍,并联系上那个人。问他,做和睦方法真的能帮助挽回感情吗?多久能起效果?他告诉我,做和睦方法百分百能挽回感情,而且七天时间就能起效了。..
2024-06-13 19:30 -

2023迁安三代试管百分百生男孩费用参考,分6点向你介绍!
2023迁安三代试管百分百生男孩费用参考,分6点向你介绍!2023迁安三代试管费用约为5万-10万元。一般来说,在北京做第三代试管的费用包括术前检查的费用、促排卵费用、取卵移..
2024-08-04 09:11 -

美国和泰国的三代试管如何选择性别?百分百选择男女吗?
美国和泰国的三代试管如何选择性别?百分百选择男女吗?生男生女一直是大家怀孕时的热门话题。尤其是二胎开放以来,为了生孩子,加上一句好话,很多人都在问生男孩生女孩的..
2024-08-16 09:02 -

可丽蓝测孕笔上的第二条杠很清楚就是百分百怀男孩吗?
第二条杠很清楚并不是百分百怀男孩,因为可丽蓝测孕笔上的第二条杠很清楚只能说明说明女性体内hcg激素水平较高,怀孕时间较长,并不能代表胎儿的性别,所以这种说法是没有..
2024-09-04 09:02
微信分享
扫描二维码分享到微信或朋友圈